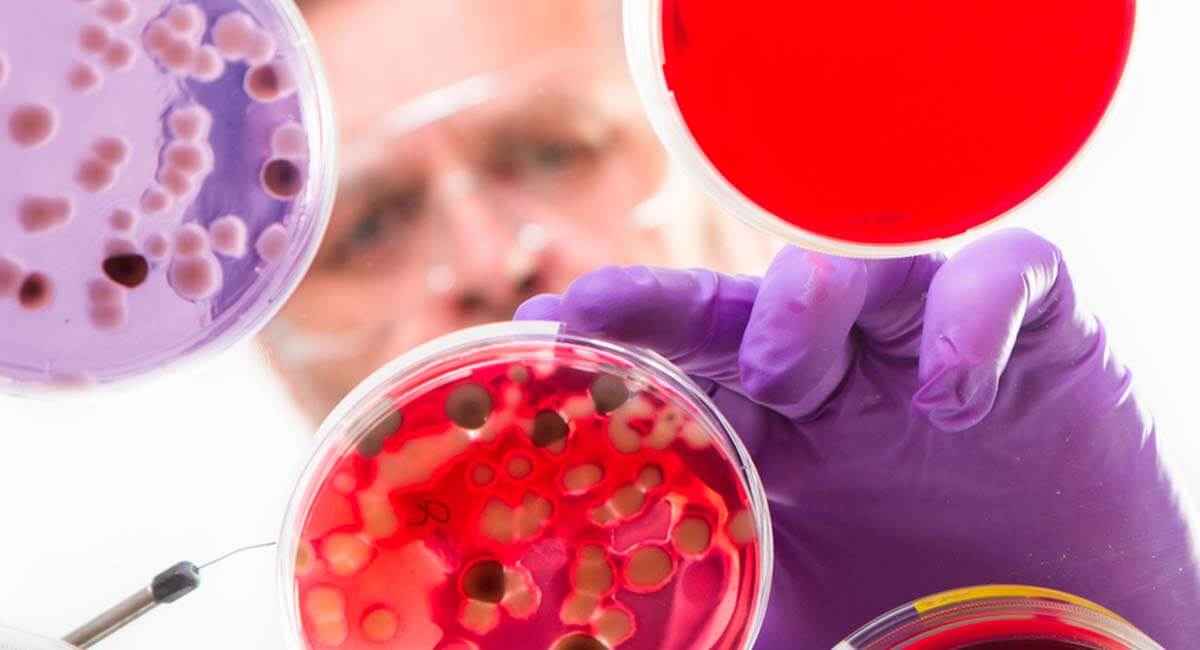
Foto de: Diplomado universitario internacional de novedades y puesta al día en enfermedades infecciosas en pediatría

🥇 Datos generales
Las enfermedades infecciosas en niños son uno de los motivos de consulta más frecuentes en pediatría, siendo la gripe una de las más comunes. Aproximadamente, 6,3 millones de niños menores de 5 años mueren cada año, el 51,8 % debido a este tipo de enfermedades.
Los profesionales sanitarios en pediatría deben tener los conocimientos necesarios para identificar, evaluar y tratar este tipo de enfermedades; así como la obligación de estar al día, no solo por los avances que se lleven a cabo en términos de tratamiento, sino porque las enfermedades infecciosas en niños implican una gran variabilidad y, a menudo, están sujetas a continuos cambios. A esto hay que sumarle el desarrollo de las vacunas durante los últimos años, una cuestión imprescindible en esta área.
Este programa formativo ofrece contenido teórico-práctico actualizado en enfermedades infecciosas en pediatría. Desde un amplio recorrido por las enfermedades virales, bacterianas, parasitarias y aquellas producidas por hongos, nociones sobre vacunas y antibióticos, hasta recomendaciones sobre cómo diagnosticar, tratar y actuar ante cada una de ellas en la población infantil.
✔️ Requisitos de acceso
- Copia del DNI, TIE o Pasaporte.
📆 Plazo inscripción
La inscripción en este curso online / a distancia permanecerá abierta durante todo el año.
⌚ Duración
El discente tendrá un tiempo máximo de 6 meses para la realización de este programa formativo.
📝 Evaluación
La evaluación estará compuesta:
- 105 Preguntas tipo test.
El alumno debe finalizar el curso y hacerlo con aprovechamiento de, al menos, un 50% de los test planteados en el mismo.
🎓 Destinatarios
A quién está dirigido el Diplomado universitario internacional de novedades y puesta al día en enfermedades infecciosas en pediatría
Este programa formativo online / a distancia está dirigido a todo aquel personal de:
- Diplomados/as o graduados/as en enfermería.
- Licenciados/as o graduados/as en medicina.
- Técnico superior de laboratorio.
🎯 Objetivos
Objetivos generales
- Proporcionar una descripción concisa y manejable de las enfermedades infecciosas más frecuentes de los niños, conociendo además el manejo y tratamiento de las mismas.
- Actualizar los conocimientos sobre los patógenos que causan enfermedad en el niño y los fármacos que actúan sobre ellos.
Sobre los Profesores

Rafael Ceballos Atienza
Tutor de esta Formación
Doctor en Medicina y Cirugía por la Universidad de Granada (España).

Sonia Baeza García
Tutora de esta Formación
Graduada en Psicología por la Universidad de Granada (España) y Técnico Superior en Salud Ambiental.

Juan Ramón Ledesma Sola
Tutor de esta Formación
Técnico Auxiliar en cuidados de enfermería.

Inmaculada Gonzalez Funes
Tutora de esta Formación
Graduada en Enfermería por la Universidad de Jaén (España).
Relacionados que te pueden interesar

Diplomado Internacional: 400 Horas, 16 Créditos ECTS
Diplomado universitario internacional en enfermedades infecciosas virales

Diplomado Internacional: 200 Horas, 8 Créditos ECTS
Diplomado universitario internacional de enfermedades infecciosas: Recogida de muestras

Diplomado Internacional: 350 Horas, 14 Créditos ECTS
Diplomado universitario internacional en mindfulness para personal de salud

Diplomado Internacional: 400 Horas, 16 Créditos ECTS
Diplomado universitario internacional en gestión, organización y prevención de riesgos laborales sanitarios

Diplomado Internacional: 250 Horas, 10 Créditos ECTS
Diplomado universitario internacional de atención urgente en pediatría

Experto Internacional: 750 Horas, 30 Créditos ECTS